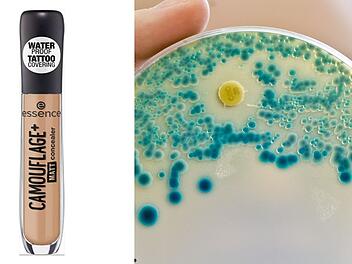
Concealer-R&uuml;ckruf wegen mikrobiologischer Keime

„Mit dem ersten Klick zu Antworten auf deine Fragen aus und über Franken – mit Produkten, die weiterhelfen und Spaß machen.“
- Das ist unsere Vision, die uns täglich leitet.
Die inFranken.de-Redaktion veröffentlicht täglich News und nützliche Informationen aus Franken und für Franken. Unser Herz schlägt für die Region, aber auch über Ereignisse außerhalb unserer Heimat berichten wir und brechen diese herunter: Was bedeuten sie für die Menschen in Franken?
Im Minutentakt bereitet die Redaktion aktuelle Meldungen aus Franken und der Welt auf, um die Nutzer*innen schnell zu informieren. Komplexe Newsthemen werden mit Infografiken, Umfragen, Live-Streams & Videos verständlich erklärt. So werden auch Themen - wie die Entwicklung der COVID-19-Pandemie – schnell und kompakt an die Nutzer*innen weitergegeben.
Zu den Nachrichten bieten wir auch nützliche Informationen zum Alltag und Service-Inhalte zu Freizeit und Tourismus in Franken. Wir sind Alltagshelfende und bieten nützliche Informationen für Franken und alle, die in unserer Region leben oder sich für Franken interessieren. Hier finden Nutzer*innen das, was das Leben für sie noch besser macht.
Diese Themen umfassen hilfreiche Alltagstipps, lokale Gastronomie & Ausflugsziele, Beiträge zu Sport & Gesundheit sowie Infos zu Produktrückrufen und Verbrauchertests.
Die Redaktion erreicht mit ihren Inhalten monatlich rund 9 Millionen Menschen und ist auch für die sozialen Kanäle Facebook, Instagram, Twitter & YouTube verantwortlich. Hier erreichen wir insgesamt knapp 500.000 Follower*innen.
Wir sind aktuell, bieten Erklärungen und ordnen ein. Wir sind uns der Verantwortung, die wir als journalistisches Angebot und Serviceportal tragen, bewusst. Deshalb berichten wir ausgewogen, fair uns sind dabei meinungsstark. Das ist unser Team: